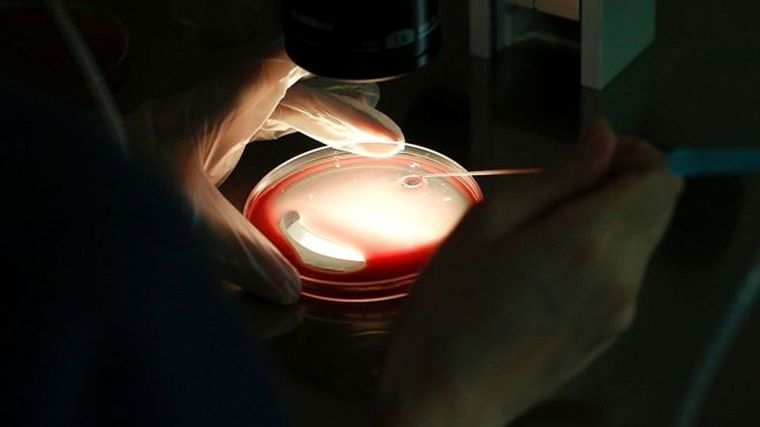
Foto: AFP

¿Por qué la concepción del bebé de "tres padres" se realizó en México?
Ha sido calificada de "revolucionaria" y ha permitido el nacimiento de un bebé con el ADN de tres personas diferentes.
Se trata de nueva y controvertida técnica de reproducción asistida (TRA) divulgada este martes por la revista NewScientist y que pudo ser llevada a cabo en México debido a un cuestionado vacío legal que existe en la nación latinoamericana.
El bebé, que ahora tiene cinco meses, cuenta con el ADN normal de su madre y su padre, más una pequeña porción de material genético de una donante.
-
Te puede interesar
Cuánto cobran jubilados y pensionados de Anses en mayo con el bono
La técnica que permitió su nacimiento, que hace que los padres con mutaciones genéticas raras puedan tener hijos sanos, está prohibida en Estados Unidos y acaba de ser legalizada en Reino Unido.
Algunos expertos advierten del peligro de que este tipo de "donación mitocondrial" degenere en la concepción de "bebés de diseño".
México es un popular destino de turismo médico en cuestiones de infertilidad y TRA, por los precios competitivos y la falta de regulación en la materia, pese a los continuos llamados para que se legisle.
El propio doctor John Zhang, responsable del tratamiento del bebé, aseguró a New Scientist que eligieron México, por que "no hay regulaciones".
Pero esta criatura podría ser la última de su tipo en nacer en el país americano, pues en el Congreso mexicano avanza una legislación con la que se quieren prohibir ciertas TRA.
Un síndrome letal y una técnica polémica
Los padres del bebé nacido en México, que tiene el ADN normal de su madre y su padre, más una pequeña porción de ADN mitocondrial de una donante (0,1%), recurrieron a la clínica New Hope Fertility Center en Nueva York (EE.UU.) que cuenta con filiales en suelo mexicano.
BBC Mundo contactó con las oficinas de la clínica en Ciudad de México y Guadalajara, y desde allí se aseguró que estaba prevista la realización de una conferencia de prensa para esta semana pero que por el momento no iban a brindar información.
Los padres del bebé, de origen jordano, fueron tratados por un equipo de estadounidenses y al menos un mexicano en México, y lograron asegurarse de que naciera sin la enfermedad genética de la madre, el síndrome de Leigh, un trastorno letal que afecta el desarrollo del sistema nervioso.
Estos genes están ubicados en el ADN de la mitocondria, el llamado "motor" de las células. Cerca del 25% de la mitocondria de la madre de este bebé tiene la mutación que causa la enfermedad y, aunque ella está sana, el síndrome causó la muerte de sus dos primeros hijos.
El doctor John Zhang retiró el núcleo de uno de los óvulos de la madre y lo insertó al óvulo de una donante al cual se le había extraído su propio núcleo. El óvulo resultante, con ADN nuclear de la madre y ADN mitocondrial de la donante, fue fertilizado con el esperma del padre.
El doctor creó cinco embriones pero sólo uno se desarrolló de forma normal, que fue implantado en la madre. Esta técnica no es legal en Estados Unidos así que Zhang fue a México.
Tras aprobarlo el año pasado, Reino Unido es el único país del mundo que permite el nacimiento de bebés con ADN de tres personas mientras que en EE.UU. el tratamiento de reemplazo mitocondrial fue legal hasta 2002.Image copyrightAFPImage captionSe estima que en el mundo hay apenas entre 30 y 50 personas con mitocondrias -y por lo tanto ADN- de una tercera persona.
Ese año la Administración de Alimentación y Fármacos (FDA, por sus siglas en inglés), les pidió a las clínicas que dejaran de hacer la transferencia citoplasmática debido a cuestiones éticas y de seguridad.
El enrevesado caso mexicano
Al no estar reguladas las TRA en México se ha abierto un campo para la experimentación.
En el país existen leyes que regulan aspectos de sanidad, por ejemplo, de las más de 50 clínicas donde se realizan estos procedimientos que son aprobadas y controladas por la Comisión Federal para la Protección contra Riesgos Sanitarios (Cofepris).
Sin embargo, "no hay una ley que vigile todos los aspectos de la reproducción asistida", le dice a BBC Mundo la académica Sandra González Santos, especialista en la reproducción asistida en México e investigadora externa del Programa Universitario de Bioética de la Universidad Nacional Autonóma de México (UNAM).
La regulación de la reproducción asistida ha estado a debate en México desde 1999 y se han presentado unas 20 propuestas de ley que no se llegaron a concretar.
La semana pasada la Comisión de Salud de la Cámara de Diputados aprobó una iniciativa, que debe pasar al pleno de la cámara y luego al Senado, que introduce reformas a la Ley General de Salud.
El diputado Elías Octavio Iñiguez Mejía, presidente de la comisión, señaló días atrás que tan sólo en 2012 se realizaron 82.000 procedimientos de reproducción asistida en el país, un promedio de 225 al día, y que en México existen 1,5 millones de parejas con problemas de infertilidad.
La regulación de la reproducción asistida ha estado a debate en México desde 1999.
Las reformas incluyen la regulación de la práctica de subrogación del vientre materno y establecen ciertas prohibiciones en materia de reproducción humana médicamente asistida.
La promotora de la iniciativa, la diputada Sylvana Beltrones, le dice a BBC Mundo que se busca "prohibir las técnicas de transferencia pronuclear que permite embriones triparentales porque se pueden crear muchos abusos al estar experimentando".
"Necesitamos regular"
"Me consternó lo que dijo el señor Zhang de que vino a México porque no hay reglas, esto no puede seguir pasando en nuestro país, no podemos ser un país donde la libertad se confunde con libertinaje", señala.
De aprobarse, considera Beltrones, no se podría repetir un caso como el dado a conocer este martes.
Sin embargo, a criterio de María de Jesús Medina-Arellano, abogada e investigadora del Instituto de Investigaciones Jurídicas de la UNAM, el proyecto carece de "tecnicismo científico" y al "prohibir cosas generales, vagas y ambiguas"va a permitir que las clínicas sigan operando y experimentando "porque va a ser muy fácil" evadir la norma.
"Lo que necesitamos no es prohibir sino regular de manera separada la reproducción asistida", agrega.
"El turismo médico", apunta la diputada, "me parece muy bueno siempre y cuando sea con procedimientos probados y seguros con la protección de la Secretaría de Salud, no una técnica donde dejes en una incertidumbre a la pareja y al niño".
La investigadora González Santos defiende que en el país las TRA existentes son "muy buenas", pero que la falta de regulación hace que puedan "proliferar las clínicas y que médico y paciente estén desprotegidos".
En la práctica, dice que son las propias clínicas las que se protegen al autorregularse siguiendo lineamientos de la Asociación Mexicana de la Medicina de la Reproducción (AMMR) y de la Red Latinoamericana de Reproducción Asistida (Redlara).
Sobre las cuestiones éticas de si la técnica aplicada en México abre la puerta a la modificación genética de humanos, señala que esa parte del debate no se aplica a ese experimento.
"Esta técnica en particular", explica, "no sirve para elegir color de ojos o la altura, sirve para tener mitocondrias sanas. Pensar que alguien puede diseñar a un bebé es pensar la biología de una manera muy simplista".







